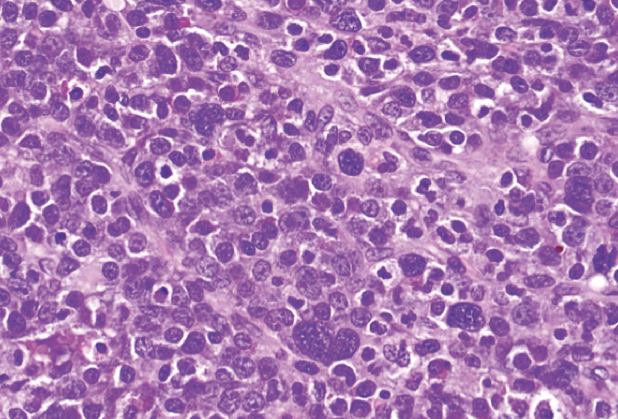
EML

Colonic Extramedullary Leukemia
Authors:
Michael M. Skaret, MD; Mary L. Kwok, MD; and Manish B. Singla, MD
Walter Reed National Military Medical Center, Bethesda, Maryland
Steven P. Armbruster, MD
Naval Hospital Jacksonville, Florida
Citation:
Skaret MM, Kwok ML, Singla MB. Colonic extramedullary leukemia. Consultant. 2018;58(4):156-157.
A 79-year-old man presented with a 3-week history of weakness and fatigue. He had a remote history of esophageal squamous cell carcinoma that had been treated with chemoradiotherapy, and prostate cancer that had been treated with surgery. Multiple therapies for ulcerative pancolitis (including thiopurines) had failed, but his disease had been well controlled for 3 years with infliximab monotherapy until he developed dose-limiting pancytopenia.
Results of a bone marrow biopsy demonstrated myeloid dysplasia and 5% blasts, consistent with myelodysplastic syndrome (MDS) with a partial deletion of the long arm of chromosome 5 (del[5q]). Additional karyotypic abnormalities also were identified, including trisomy of chromosome 8. He discontinued infliximab and began treatment with lenalidomide for del(5q) MDS.
Given his history of pancolitis, the patient underwent chromoendoscopy for routine dysplasia screening less than 2 weeks after the initiation of lenalidomide therapy. A large sessile polyp in the sigmoid colon was completely resected during the procedure, and results of histopathologic examination of the mass showed extramedullary myeloid leukemia (EML).
Surveillance chromoendoscopy after 2 months of lenalidomide therapy revealed no residual tumor, but results of a repeated bone marrow biopsy exhibited clonal evolution indicative of progression to acute myeloid leukemia (AML). The patient transitioned therapy to azacitidine and has declined to undergo colectomy to date; his colitis is in remission with mesalamine monotherapy.
Discussion. EML is a rare presentation of myeloid neoplasia in solid form that is a harbinger of AML, and the sigmoid colon is an even rarer site for the development of this malignancy. Pathologically, EML is a neoplastic expansion of myeloid progenitor cells with involvement of extramedullary tissues. Myeloid sarcoma occurs when blast cells form a macroscopic collection resembling a soft tissue mass in an anatomical site outside of the bone marrow.1,2 These tumors originally had been termed chloromas due to their green hue, which is a result of the production of myeloperoxidase that is seen in many cases.3,4 EML can occur in up to 10% of AML cases, but true myeloid sarcomas likely represent less than 1% of cases.5 EML may be isolated anywhere in the body, but it most often occurs in the lymph nodes, skin, and eyes. Gastrointestinal tract manifestations, as in our patient’s case, are uncommon.2
The pathogenesis of EML has not been entirely elucidated, but it may differ somewhat from that of MDS and AML. In AML, loss of cell surface adhesion molecules is thought to contribute to the release of blast cells from the bone marrow, resulting in their circulation in the peripheral blood. In EML, additional chemokine signals allow invasion of extramedullary tissues by circulating cells, leading to the formation of myeloid tumors.3 Based on this pathophysiologic schema, invasion of extramedullary sites follows circulation of myeloid progenitor cells in the peripheral blood, so EML is thought by many to be equivalent to AML.
Rarely, primary EML may be a patient’s initial manifestation, and the appearance of EML simultaneously with the initial diagnosis of MDS is even less common.3 Deletion of the long arm of chromosome 5 is the most common karyotypic abnormality in MDS, present in approximately 15% of cases, and it has been traditionally described as an indicator of a favorable prognosis. The presence of additional karyotypic and molecular abnormalities may contribute to a poorer prognosis, even in the setting of the more favorable del(5q).6 Trisomy 8, for example, is commonly associated with EML, and its coexistence with del(5q) in this patient’s case indicates a high risk of progression to AML.3
The results of several small studies have shown that patients who have undergone cytotoxic chemotherapy or radiation therapy may be at greater risk for treatment-related myeloid sarcoma.2 Inflammatory bowel disease and the immunosuppressant medications used to treat it increase the risk of hematologic malignancy. The use of thiopurines increases a patient’s risk of lymphoproliferative disorders (eg, Hodgkin lymphoma, non-Hodgkin lymphoma, hepatosplenic T-cell lymphoma) up to 5 times, although data are limited regarding myeloid neoplasms specifically.7,8
Finally, a theoretical risk of malignancy is associated with tumor necrosis factor α (TNF-α) antagonists. This was initially described in a meta-analysis by Bongartz and colleagues, who found an increased incidence of lymphoproliferative disorders and skin cancer in patients with rheumatoid arthritis who were treated with adalimumab and infliximab.9 However, this effect has not been subsequently well established, and it should be noted that thiopurine use was a significant confounding variable in the meta-analysis.9 Nevertheless, TNF-α antagonist therapy may contribute to the risk of malignancy.
Figure: High-power (×40) view of a population of lymphoid cells with vesicular chromatin and prominent nucleoli. Larger bizarre cells with hyperchromatic nuclei and rare eosinophilic myelocytes (common in myeloid sarcoma) were also identified.
This patient’s case demonstrates the timely diagnosis of a rare malignancy in a patient with multiple risk factors. If not for this patient’s adherence to regular dysplasia screening with chromoendoscopy, his underlying myeloid sarcoma might not have been identified, and the appropriate intensification of his treatment regimen might have been delayed. EML should be considered in patients with polypoid lesions of the colon, hematologic abnormalities, and multiple risk factors.
References:
- Mohammadiasl J, Khosravi A, Shahjahani M, Azizidoost S, Saki N. Molecular and cellular aspects of extramedullary manifestations of acute myeloid leukemia. J Cancer Metastasis Treat. 2016;2:44-50.
- Peker D, Parekh V, Paluri R, et al. Clinicopathological and molecular features of myeloid sarcoma as initial presentation of therapy-related myeloid neoplasms: a single institution experience. Int J Hematol. 2014;100(5):457-463.
- Ohanian M, Faderl S, Ravandi F, et al. Is acute myeloid leukemia a liquid tumor? Int J Cancer. 2013;133(3):534-544.
- Byrd JC, Edenfield WJ, Shields DJ, Dawson NA. Extramedullary myeloid cell tumors in acute nonlymphocytic leukemia: a clinical review. J Clin Oncol. 1995;13(7):1800-1816.
- Dores GM, Devesa SS, Curtis RE, Linet MS, Morton LM. Acute leukemia incidence and patient survival among children and adults in the United States, 2001-2007. Blood. 2012;119(1):34-43.
- Giagounidis A, Mufti GJ, Fenaux P, Germing U, List A, MacBeth KJ. Lenalidomide as a disease-modifying agent in patients with del(5q) myelodysplastic syndromes: linking mechanism of action to clinical outcomes. Ann Hematol. 2014;93(1):1-11.
- Beaugerie L, Brousse N, Bouvier AM, et al; CESAME Study Group. Lymphoproliferative disorders in patients receiving thiopurines for inflammatory bowel disease: a prospective observational cohort study. Lancet. 2009;374(9701):1617-1625.
- Targownik LE, Bernstein CN. Infectious and malignant complications of TNF inhibitor therapy in IBD. Am J Gastroenterol. 2013;108(12):1835-1842.
- Bongartz T, Sutton AJ, Sweeting MJ, Buchan I, Matteson EL, Montori V. Anti-TNF antibody therapy in rheumatoid arthritis and the risk of serious infections and malignancies: systematic review and meta-analysis of rare harmful effects in randomized controlled trials. JAMA. 2006;295(19):2275-2285.
Disclaimer: The views expressed in this article are those of the authors and do not reflect the official policy or position of the Uniformed Services University of the Health Sciences; the Departments of the Army, Navy, or Air Force; the Department of Defense; or the US Government.
